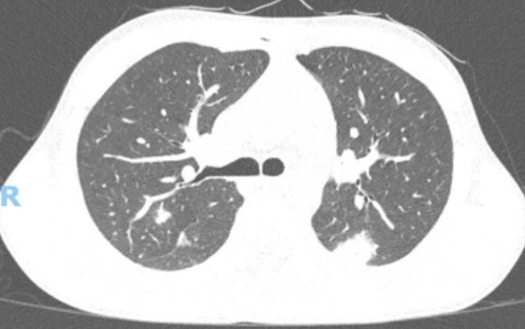

The Brazilian Journal of Case Reports (BJCR) (ISSN 2763-583X) is an international and open access journal that operates with a continuous editorial and publication flow. Adopting a rigorous double-blind peer review process, the BJCR is committed to publishing high-quality, original contributions that are of significant interest to researchers in both human and animal health. Launched in 2021, the BJCR focuses on disseminating clinical studies that present rare and noteworthy findings which contribute to advancing medical knowledge. Our aim is to provide a platform for the documentation and discussion of unusual and significant clinical cases, offering valuable insights and fostering the development of new diagnostic and therapeutic approaches.
The journal welcomes submissions that detail clinical experiences, innovative case series, and critical analyses that highlight unique medical phenomena, novel treatment methods, and complex patient scenarios. By maintaining a diverse and interdisciplinary scope, the BJCR seeks to bridge gaps between various fields of medicine and veterinary science, encouraging a holistic understanding of health and disease. The BJCR is dedicated to ensuring accessibility and visibility of its publications through open access, thereby facilitating the global exchange of knowledge and supporting the scientific community in making impactful advancements in medical research.
The Journal features the following sections (all topics may related with human or animal studies):
- Clinical Case Reports;
- Clinical Imagens Reports;
- Letter to editor (Correspondence or Comments).
Time to first decision: Two weeks.
Language: English is the official language of BJCR. However, we will also receive articles in Portuguese.
Aims and Scope
BJCR will consider any original case report that expands the field of general medical knowledge about human and/or veterinary sciences, and original review studies relating to clinical case reports.
All articles in the BJCR may follow one of the following topics, but not necessarily (all topics may related with human or animal studies):
- Rare clinical findings;
- Clinical images (ie. X-ray, CT scans, MRIs, and ultrasound);
- Clinical Laboratory findings (ie. blood analysis, and histopathology);
- Pathology diagnosis;
- Surgery procedures
Article Processing Charges
All articles published in BJCR are open access and freely available online, immediately upon publication. APC is essential to cover the costs of all journal publishing functions. The APC for BJCR is USD120,00, for foreign authors, or R$500,00 for Brazillian authors. There are no charges for Letter to editor, submission or rejected articles, and no surcharges based on the article composition (ie. color figures or number of pages).
Scientific Mission
Our mission is the publication and digital visibility of national and international scientific research in the health area, with a focus on open access publications, which seek to disseminate the results of relevant scientific studies, peer-reviewed by a qualified editorial board, valuing quality, impact and its scientific and social relevance.
If you have any questions, please do not hesitate to contact us at bjcasereports@gmail.com or by Whatsapp (+558599186-4030).